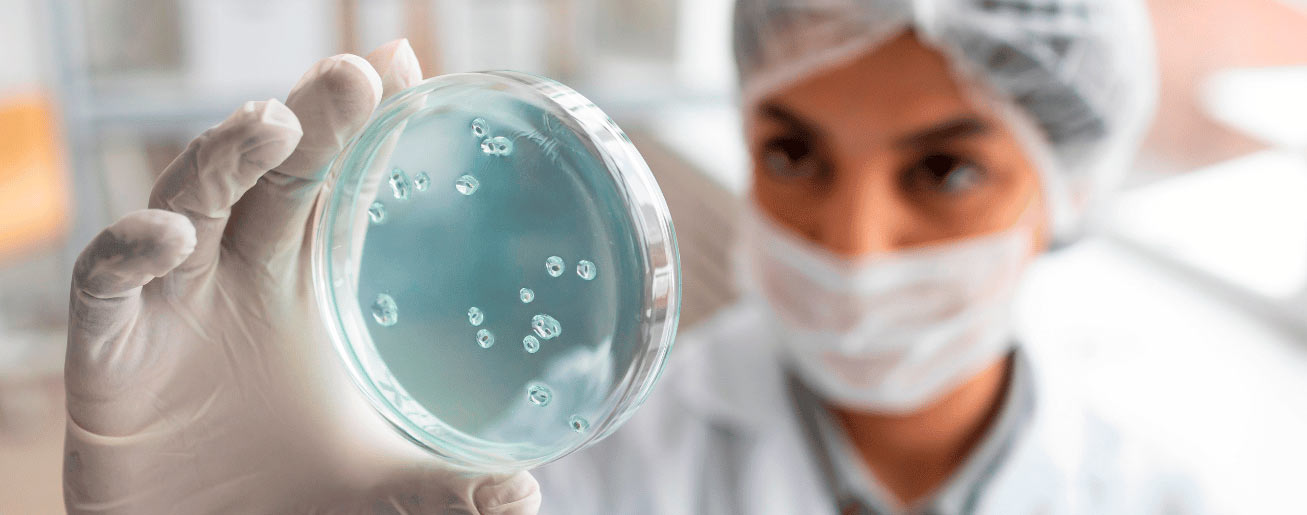
spx-clinica-spx-imagem-nova-terapia-celular-contra-o-cancer

Células CAR-T Contra o Câncer: Novo Método Ganha Força
A terapia CAR-T já é uma das maiores revoluções da oncologia moderna, e o avanço recente das pesquisas reforça ainda mais esse protagonismo. Contudo, estudos de pesquisadores do A.C Camargo Cancer Center indicam novas estratégias para ampliar a eficácia das células CAR-T contra o câncer.
Apesar dos resultados expressivos, um dos principais desafios da terapia está no comportamento dessas células ao longo do tempo. As células CAR-T, sobretudo, podem entrar em um estado de exaustão funcional, no qual perdem gradualmente a capacidade de manter um ataque contínuo às células tumorais.
Nova Atuação das Células CAR-T contra o Câncer
A estratégia, em síntese, envolveu o uso de fármacos específicos para bloquear um complexo proteico ligado ao esgotamento das células CAR-T. Em testes pré-clínicos com animais, a abordagem apresentou resultados consistentes.
Em outras palavras, as células recuperaram vitalidade, aumentaram sua proliferação e reforçaram a capacidade de ataque às células tumorais.
Assim, a resposta contra o câncer tornou-se mais intensa e prolongada. O achado aponta caminhos promissores para potencializar essa tecnologia, tornando as terapias celulares mais eficazes, duráveis e alinhadas ao avanço da oncologia de precisão.
Inovação, Precisão e Tecnologia
A medicina contra o câncer, enfim, vive um dos momentos mais transformadores de sua história. Impulsionada por avanços científicos, biotecnologia e inteligência aplicada à saúde, então, a oncologia proporciona:
-
Terapias celulares e imunoterapia: Estratégias inovadoras, como as células CAR-T, treinam o próprio sistema imunológico para reconhecer e destruir células tumorais, marcando uma mudança de paradigma no tratamento oncológico.
-
Medicina de precisão e genética: A análise molecular dos tumores permite terapias direcionadas, mais eficazes e com menor impacto ao organismo, tornando o tratamento cada vez mais individualizado.
-
Tecnologia e exames de alta complexidade: Métodos avançados de imagem e diagnóstico precoce aumentam a assertividade clínica, permitem intervenções mais rápidas e monitoram com precisão a resposta ao tratamento.
-
Pesquisa translacional acelerada: A integração entre laboratórios, centros de pesquisa e prática clínica reduz o tempo entre descobertas científicas e sua aplicação real no cuidado ao paciente.
Referência: Portal Saúde Abril.
Participe do Canal do WhatsApp da SPX!
Gostou? Clique aqui e acompanhe outros conteúdos da SPX Clínica. Dicas de saúde, novidades e muito mais. Fique por dentro do mundo da saúde!
Últimas Notícias

Tecnologia de IA Prevê Doenças Cardíacas pela Mamografia; Veja!
Entenda como a IA prevê doenças cardíacas pela Mamografia e transforma um exame de rotina em alerta precoce às mulheres

Quais os Riscos do Vírus Oropouche na Gravidez? Entenda!
Com possibilidade de transmissão vertical da mão para o filho, saiba mais e descubra quais os riscos do vírus oropouche na gravidez

Treino Mental pode Reduzir Risco de Alzheimer; Entenda!
Um estudo que acompanhou pacientes por anos comprova que estimular o treino mental pode reduzir risco de Alzheimer. Saiba mais!

SP Deve Registrar 20 Mil Casos de Câncer de Mama em 2026
Segundo levantamento, o Estado de São Paulo pode alcançar um número elevado de casos de câncer de mama em 2026. Veja detalhes!

Nanopartícula é Capaz de Eliminar Tuberculose? Saiba Mais!
Um estudo com animais evidencia como uma nanopartícula é capaz de eliminar tuberculose em até 30 dias. Confira!

Inovação: Realidade Aumentada Contra Tumores Cerebrais
A utilização da realidade aumentada contra tumores cerebrais permite uma abordagem mais segura na neurocirurgia. Entenda!